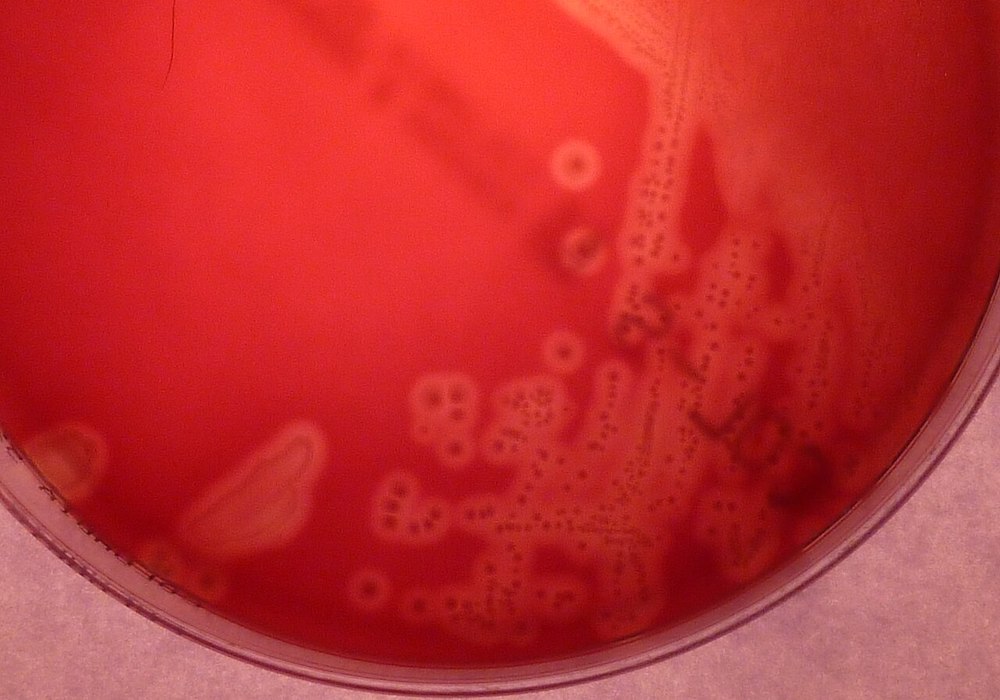

Agência Bori
- Estudo da UFPB revela que amostras da bactéria Streptococcus agalactiae resistentes à eritromicina saltou de 11% para 42% em cinco anos
- O aumento ocorreu de forma indireta, impulsionado pelo uso em larga escala de medicamentos como a azitromicina
- A falha na prevenção de infecção durante o parto pode causar infecções graves em recém-nascidos, como meningite e sepse
Streptococcus agalactiae em ágar de sangue (foto: 43trevenque – CC BY-SA 4.0)
O uso de antibióticos por conta própria é um problema de saúde pública que ganhou novas proporções durante a pandemia de covid-19. Embora muitas pessoas tenham buscado esses medicamentos para tratar a infecção viral, o impacto real apareceu de forma silenciosa em bactérias que já habitam o corpo humano, criando microrganismos muito mais difíceis de combater.
Um estudo conduzido por pesquisadores da Universidade Federal da Paraíba (UFPB), publicado na Revista da Sociedade Brasileira de Medicina Tropical, monitorou gestantes de alto risco no Hospital Universitário Lauro Wanderley entre 2020 e 2024. A pesquisa descobriu que a bactéria Streptococcus agalactiae, comum no organismo feminino, apresentou um salto alarmante de resistência à eritromicina, que quase quadruplicou entre as amostras, no período analisado.
“A eritromicina não é utilizada para tratar essa bactéria, mas como ela é uma molécula muito similar à azitromicina usada de forma indiscriminada na comunidade durante a covid-19, isso serviu como um combustível para que esses microrganismos se tornassem resistentes”, explica Vinícius Perez, pesquisador vinculado à UFPB e à UFRGS, e um dos autores do trabalho.

Comprimidos parecem inofensivos, mas o uso sem orientação acelera a perda de eficácia contra infecções graves (foto: Freepik)
A bactéria em questão costuma habitar o intestino e a região genital de muitas mulheres, sem causar danos à saúde. O perigo surge no momento do parto: se a gestante estiver colonizada e não receber a proteção correta com antibióticos, o bebê pode ser infectado ao passar pelo canal de nascimento. Como o sistema imunológico do recém-nascido ainda está em desenvolvimento, a infecção pode ser letal.
“Em recém-nascidos, essa bactéria é uma causa de infecções extremamente graves, como a sepse, meningite e pneumonia. É um quadro difícil de diagnosticar logo nos primeiros dias de vida”, afirma o pesquisador.
O tratamento padrão continua sendo a penicilina, que ainda se mostra eficaz. No entanto, o estudo acende um alerta para as gestantes alérgicas ao medicamento. Para esse grupo, as alternativas seriam justamente a eritromicina ou a clindamicina, que agora apresentam falhas de eficácia devido à alta resistência observada.
“Hoje ainda podemos usar a penicilina, mas, se um dia não pudermos mais, teremos um grande problema. Observamos que os outros antibióticos começaram a se mostrar menos eficazes do que eram até alguns anos atrás”, diz Perez.
Atualmente, o SUS não garante o teste de triagem para todas as gestantes, sendo recomendado obrigatoriamente apenas para casos de alto risco. Isso cria uma lacuna de segurança para as demais mulheres que dependem da rede pública.
O próximo passo para as políticas públicas de saúde, dizem os autores, é a avaliação da universalização desse teste no pré-natal. Enquanto isso, a recomendação é que as gestantes questionem seus médicos sobre a realização do exame entre a 35ª e a 37ª semanas de gestação.



